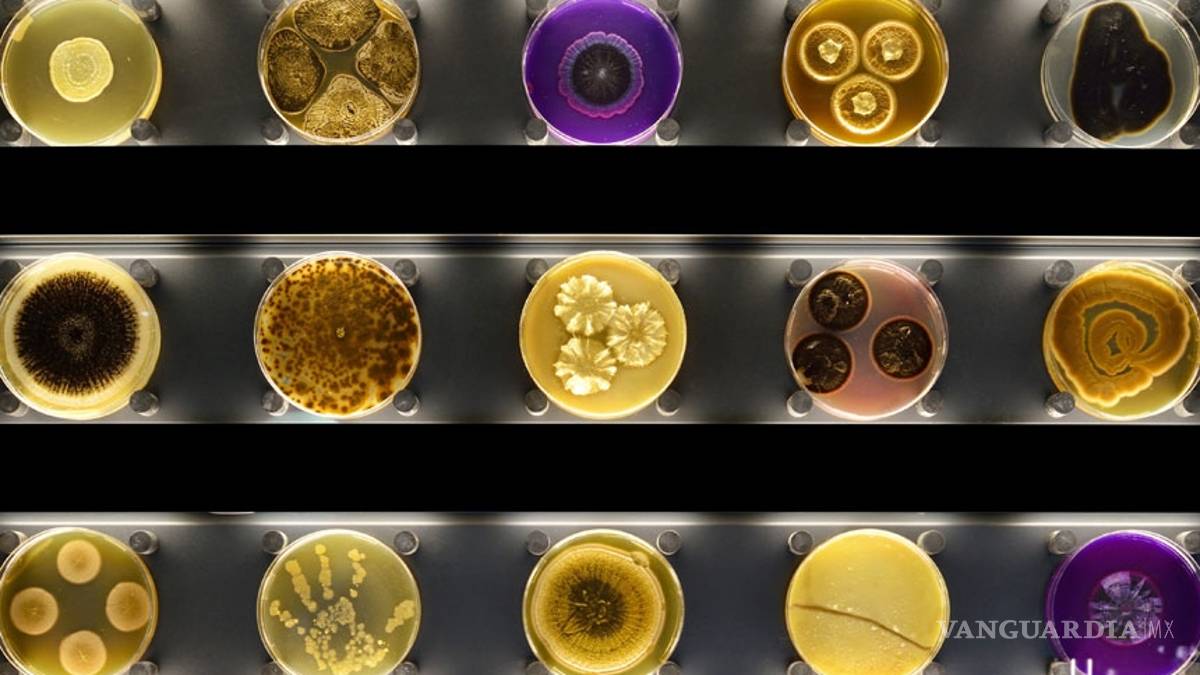

Micropia, el museo de los seres vivos invisibles
COMPARTIR
Los microbios desde ahora cuentan en Holanda con su primer zoo en el mundo, el museo Micropia.
Madrid, España.- Nos rodean, incluso habitan en nuestra piel, pero es mejor no pensar en ellos porque, de lo contrario, nos convertiríamos en seres obsesionados por la limpieza o andaríamos cubiertos hasta la cabeza con trajes aislantes ante el miedo a contagiarnos.
Pero hay que saber que, pese a que echemos mano de los trajes más avanzados contra el contagio, los microorganismos (cualquier ser vivo que solo es posible visualizarlo con microscopio) siempre nos acompañarán, por fortuna en la mayoría de los casos.
Virus, bacterias u hongos son fuente de vida o de muerte pero, en todo caso, siempre son necesarios para la vida  del cualquier ecosistema del planeta y, por ende, del ser humano.Â
En este sentido, estos protagonistas de los más importantes estudios sobre la salud humana, no tenían hasta ahora un museo donde conocer más a fondo su origen, su estudio y sus funciones, y, como no, un lugar donde su aspecto invisible al ojo humano fuera subsanado para que estuvieran al alcance de cualquier mirada curiosa y ajena al mundo científico.Â
Y eso hasta ahora porque Amsterdam (Holanda) ha sido la primera ciudad del mundo en abrir un museo dedicado al conocimiento y estudio de los microorganismos, el Museo Micropia, un espacio que se sitúa dentro del Artis Royal Zoo y que pone a disposición de los visitantes toda la información hasta ahora reservada a los estudiosos de la materia.Â
Además, Micropia llega en un momento en el que nos hemos familiarizado con nombres de microorganismos, en su mayoría malos para la salud, como la gripe A o, más recientemente, el ébola.Â
Pero también llega en un momento en el que, como en el caso de los recientes contagios de ébola, hemos visto como los propios virus son también fuente de antídotos; o en un momento en el que los yogures llevan probióticos, las llamadas bacterias buenas para la vida.Â
ESOS PEQUEÑOS SERES
Como se puede conocer durante la visita a Micropia, alrededor de 700 especies de bacterias viven en nuestra boca, y más de 100,000 millones de microorganismos, pertenecientes a más de 1,000 especies diferentes, están  en cada centímetro cuadrado de nuestra piel.Â
Así que, teniendo en cuenta que sin estos no podría haber vida en la tierra, este espacio pone a disposición del visitante la posibilidad de vernos cubiertos por esos bichitos que representan dos terceras partes de los seres vivos que pueblan el planeta.
Como si de un juego interactivo se tratase, uno de los mayores atractivos de este centro es, sin duda, colocarse delante del escáner y esperar a ver cómo nuestra silueta se empieza a llenar de puntos de colores hasta que una leyenda te dice la cantidad de bacterias que viajan contigo.Â
El zoo en miniatura de Amsterdam se proclama también como un auténtico museo interactivo que tiene como objetivos conectar la "ciencia con los estudiantes", así como "estimular estudios científicos", tal y como apunta el centro en su página web.
Asimismo, teniendo en cuenta que están en nosotros cuando comemos, respiramos o besamos, el museo propone un recorrido lleno de colores por este mundo invisible. Â
Colores y formas, porque cada organismo puede ser observado por el visitante con microscopios y otros instrumentos para conocer cómo viven en cada lugar del mundo, o cómo un hongo crece en todas las direcciones hasta encontrar la vía más rápida para alimentarse.
Pero, como el propio museo indica, el origen de todo está en el siglo XVII cuando comenzó el estudio de esta materia por parte del holandés Antoni van Leeuwehnhoek, el primer buscador de microbios que hizo referencia a ellos como "animacules" (que procede del latín "animal-culum", pequeños animales).
Y si Antoni van Leeuwehnhoek levantara la cabeza seguramente no daría crédito a lo que ve, ya que se trata de un museo donde la ciencia se da la mano con el diseño, el mejor aliado para mostrarse en toda plenitud.
UN PROYECTO AMBICIOSO
Tras el nacimiento de este museo interactivo de microbios, en el que podemos hallar la solución a preguntas como qué forma tiene el microorganismo que lucha contra el cáncer, hay un gran trabajo hecho durante 12 años y una inversión de unos 10 millones de euros (12,4 millones de dólares).
Un proyecto ambicioso en el que también se cuenta con un laboratorio que puede ser contemplado por los visitantes a través de un gran ventanal. Personas que también podrán sentirse científicos poder mirar los microorganismos a través de varias filas de microscopios 3D diseñados especialmente para el museo.
La ambición de Micropia de ser didáctico le ha llevado a aliarse con el artista británico Luke Jerram para elevar a la categoría de arte virus como el sida o ébola.Â
Jerram ha elaborado modelos de cristal a gran escala de estos virus que cuentan con el atractivo de convertirse en pequeñas esculturas.Â
Y si el artista británico ha sido el encargado de unir arte y ciencia, el responsable de darle forma al continente de Micropia ha sido el holandés Mark de Jong, de la agencia Kossmanndejong, quien desde 2006 ha estado trabajando con el reto de "¿cómo contar la historia de un inmenso mundo invisible?".
Con esta pregunta como guía, para lograr hacer que los virus sean los "reyes" del museo han creado zonas de sombras con pequeños puntos de luces flourescentes para resaltar la presencia de los microbios, virus u hongos, es decir, de todos los microorganismos que pueblan este museo no apto para hipocondriacos.
DESTACADOS:
+++ Amsterdam (Holanda) ha sido la primera ciudad del mundo en abrir un museo dedicado al conocimiento y estudio de los microorganismos, el Museo Micropia.
+++ Alrededor de 700 especies de bacterias viven en nuestra boca, y más de 100,000 millones de microorganismos, pertenecientes a más de 1,000 especies diferentes, están en cada centímetro cuadrado de nuestra piel.
+++ Micropia cuenta con un laboratorio que puede ser contemplado por los visitantes a través de un gran ventanal.
Pilar Martín-Valverde/EFE-Reportaje
